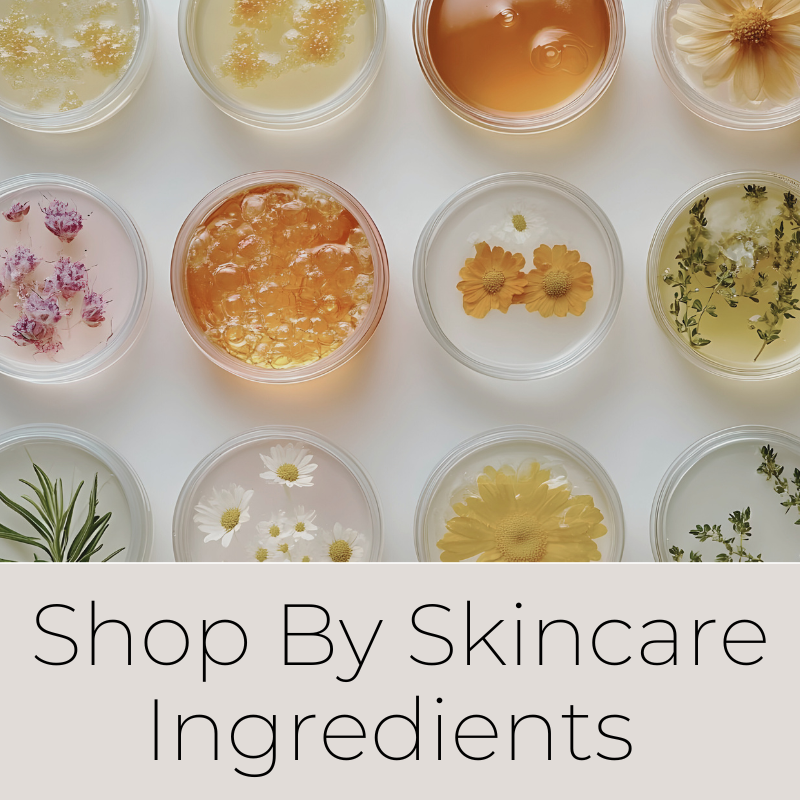

Shop By Category

Just for you.

You'll love these.

Fresh on the site

Try new products.

Great deals here.
You don't have to be your own skincare lab.
20+ years of curating the cleanest brands, so you can skip the trial-and-error phase.
Small Shop. Big Love.
New to Lilou? We made a page just for you →